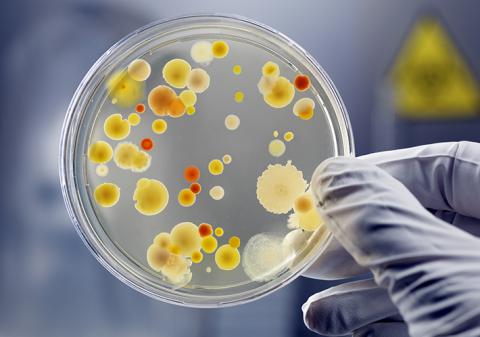
News image

Mar 22, 2022
ASTM International’s committee on pesticides, antimicrobials, and alternative control agents (E35) has approved a new standard that will be used to help mimic how surfaces are contaminated by microbial material. The new standard will soon be published as E3285.
“Many existing test methods employ long contact times, high concentration of bacteria, or immersion in fluid,” says ASTM International member Christopher Jones, Sharklet Technologies. “In our experience, these approaches do not reflect surface contamination in the real world. This method addresses that gap.”
The standard is based on a surface that mimics the texture of shark skin. “There are many examples of biomimicry emerging in a wide variety of fields, from physics to engineering to biology,” says Jones.
Jones notes that the new method used a piece of paper soaked in a low concentration of bacteria to contaminate a test surface. The short contact time, diluted bacteria, and low amount of moisture accurately mimic how most surfaces are contaminated. The new standard will be useful to anyone concerned with contamination of surfaces, including manufacturers, regulatory bodies, consumers, academics, and testing laboratories.
The committee will be conducting an interlaboratory study (ILS) in the next five years to establish reproducibility among labs. All interested laboratories are invited to take part in this ILS.
To purchase standards, contact ASTM International customer relations (tel +1.877.909.ASTM; sales@astm.org).
U.N. Sustainable Development Goal Supported:

May / June 2022